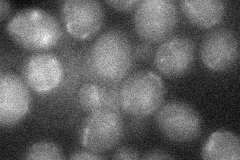
YPL230W
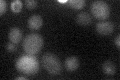
YPL230W

View description
Putative transcription factor containing a C2H2 zinc finger; mutation affects transcriptional regulation of genes involved in growth on non-fermentable carbon sources, response to salt stress and cell wall biosynthesis
Localization:
Intensity:
Fold change:
Significance:
-
C’ GFP library in SD

below threshold17.24 -
N' NOP1pr-GFP in SD

nucleus48.7602 -
N' TEF2pr-mCherry in SD

nucleus15.9911 -
N' NATIVEpr-GFP in SD

nucleus17.4927 -
N' TEF2pr-VC and Cyto-VN in SD
below threshold28.5759 -
C’ GFP library in SD+DTT

cytosol15.540.9No -
C’ GFP library in SD+H2O2

cytosol17.080.99No -
C’ GFP library in Starvation Media
cytosol28.971.68No -
C’ GFP library on the background of Pup2-DaMP

below threshold -
C’ GFP library on the background of CCT mutant

below threshold17.53451.01667No
